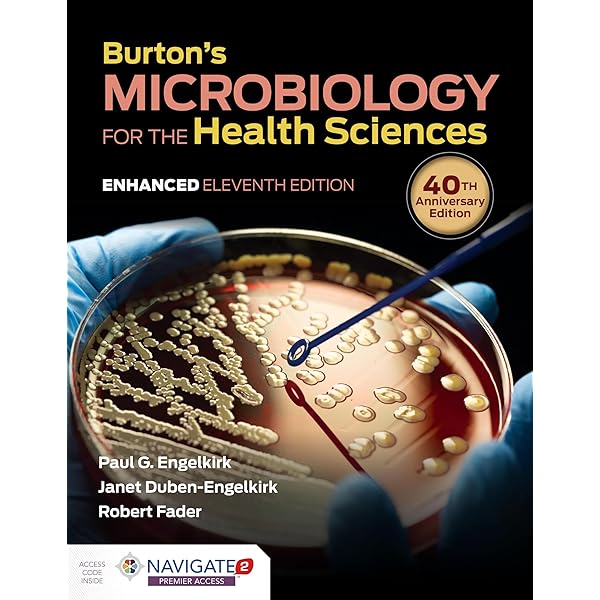
ITLS 英語版　Ninth Edition ITLS for Emergency Care Providers – 9th Edition - ITLS

マイストア
変更
お店で受け取る
(送料無料)
配送する
納期目安:
2026.01.17 13:37頃のお届け予定です。
決済方法が、クレジット、代金引換の場合に限ります。その他の決済方法の場合はこちらをご確認ください。
※土・日・祝日の注文の場合や在庫状況によって、商品のお届けにお時間をいただく場合がございます。
ITLS 英語版 Ninth Edition ITLS for Emergency Care Providers – 9th Edition - ITLSの詳細情報
ITLS for Emergency Care Providers – 9th Edition - ITLS。International Trauma Life Support for Emergency Care。Collins コウビルド英英辞典 第9版 - メルカリ。緊急医療提供者向けの国際的な外傷生命維持の教科書。- タイトル: INTERNATIONAL Trauma Life Support- 版: Ninth Edition- 著者: ROY L. ALSON, KYEE HAN, JOHN E. CAMPBELL- 対象: Emergency Care ProvidersAmazon購入価格 税込 16,556円。International Trauma Life Support for Emergency Care
ベストセラーランキングです
近くの売り場の商品
カスタマーレビュー
オススメ度 4.5点
現在、2915件のレビューが投稿されています。

![ジョジョの奇妙な冒険 全巻1-63巻セット[完]/美品/J01](https://static.mercdn.net/item/detail/orig/photos/m42829264078_1.jpg)









